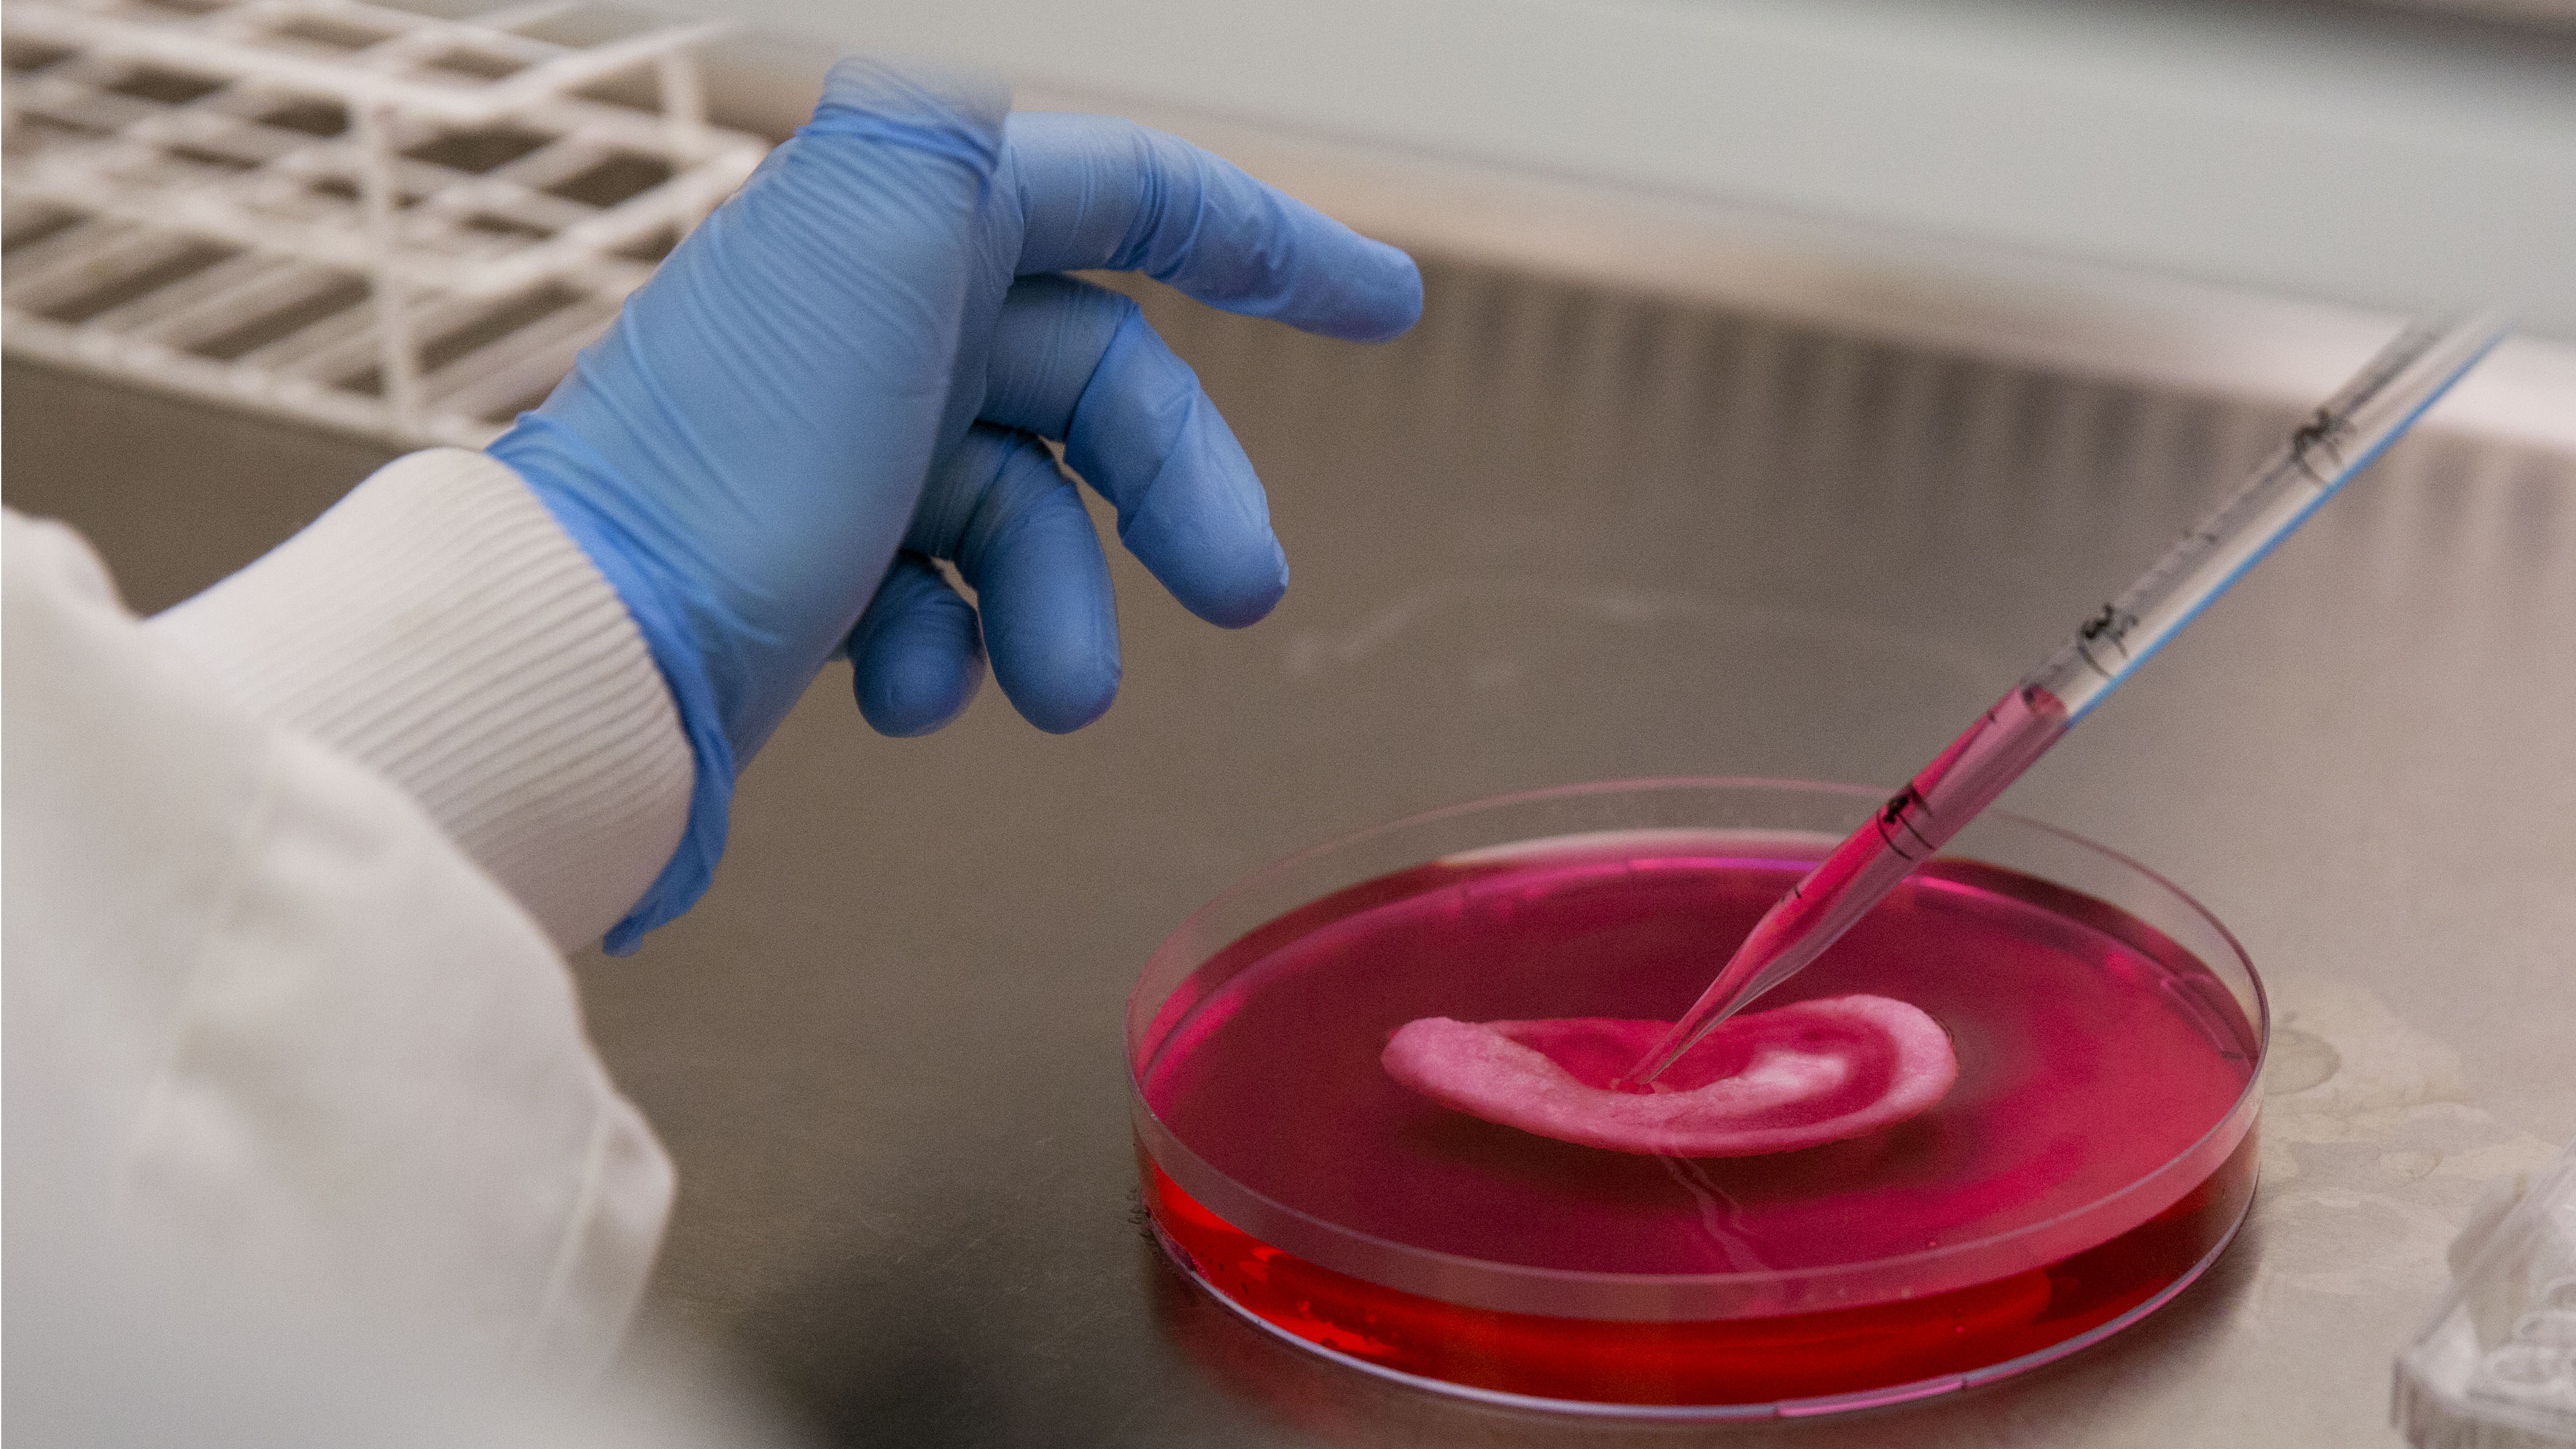

The predicted fall in international students at British universities will have a damaging effect on the wider research and development environment, according to research and analysis by the Higher Education Policy Institute (HEPI) and Richard Jones of the University of Manchester.
Along with businesses, there is a growing call for universities to be "bailed out" as the COVID-19 lockdown threatens incomes across sectors and - worryingly for the education sector - threatens the possibility for international students to make their way to the country of their choice.
The higher education sector in the UK is financed with a mix of publicly and privately paid student fees, along with research grants and funding from businesses and organizations like Research England.
Funding for research in the UK is potentially threatened by a decline in overseas students. (AP Photo/Matt Dunham)
Funding for research in the UK is potentially threatened by a decline in overseas students. (AP Photo/Matt Dunham)
The full cost of UK research is staggeringly high, and according to HEPI research, there is a gap of $5.3 billion between what universities are paid to conduct it, and what the research actually costs.
The shortfall is made up by what is known as "cross-subsidies" from the fees paid by international students. Their fees are around $6,000 more than UK or EU students, for the latest academic year. That creates a $1.7 billion surplus - the difference between how much international students pay to institutions, and how much it costs to teach them.
With fears that up between 80 and 100 percent of international students will not arrive in September, at the start of the next academic year, Richard Jones told CGTN Europe he wanted to make their importance clear.

How international student fees and research budgets compare /Richard Jones of the University of Manchester / @RichardALJones
How international student fees and research budgets compare /Richard Jones of the University of Manchester / @RichardALJones
"I don't think everyone in the UK government fully understands how important international students have been to the success of the UK higher education system over the last decade, and I wanted to make that point very graphically with my chart," he said.
Writing earlier this year, Nick Hillman of the London-based HEPI explained how any drop in international student numbers would impact research funding, at least in part thanks to a reorganization of UK students' fees.
"Universities roughly break even on teaching home students but make a big loss on research. They fill in part of that gap from the surplus on teaching international students. But they now face a looming large loss on teaching home students, for example because of tweaks to tuition fees in England. If that happens, they will have to use international student fees to subsidize home students and there will be less money for covering gaps in research funding."
Hoping to reassure UK institutions, Liu Xiaoming, the Chinese ambassador to the UK, said he had written to the vice-chancellors of 154 British and Northern Irish universities to express a commitment to "stronger relationships between Chinese universities and British universities."
Chinese students are the largest group of international students attending UK higher education institutions.